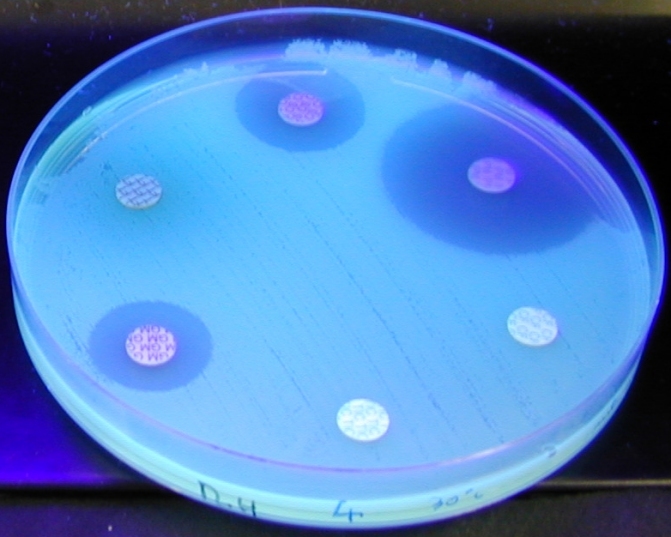
jpg antibiogramme avec fluoresceine

Un peptide contre les bactéries résistantes aux antibiotiques
 Une équipe canadienne vient de publier une nouvelle approche de lutte contre les bactéries résistantes aux antibiotiques. Cette fois ce sont les biofilms qui sont visés. Ces films biologiques produits par les bactéries rendent difficile voir impossible l'accès des antibiotiques, diminuant ainsi considérablement leurs effets.
Une équipe canadienne vient de publier une nouvelle approche de lutte contre les bactéries résistantes aux antibiotiques. Cette fois ce sont les biofilms qui sont visés. Ces films biologiques produits par les bactéries rendent difficile voir impossible l'accès des antibiotiques, diminuant ainsi considérablement leurs effets.
Le peptide 1018, sujet de l'étude, inhiberait la formation des biolofilms par la bactérie et détruirait également les biofilms existants. Le peptide serait également efficace sur des souches particulièrement résistantes de P. aeruginosa, d' E. coli et de S. aureus.
SOURCE : PLOS Pathogens
Une équipe canadienne vient de publier une nouvelle approche de lutte contre les bactéries résistantes aux antibiotiques. Cette fois ce sont les biofilms qui sont visés. Ces films biologiques produits par les bactéries rendent difficile voir impossible l'accès des antibiotiques, diminuant ainsi considérablement leurs effets.
Une équipe canadienne vient de publier une nouvelle approche de lutte contre les bactéries résistantes aux antibiotiques. Cette fois ce sont les biofilms qui sont visés. Ces films biologiques produits par les bactéries rendent difficile voir impossible l'accès des antibiotiques, diminuant ainsi considérablement leurs effets.
Le peptide 1018, sujet de l'étude, inhiberait la formation des biolofilms par la bactérie et détruirait également les biofilms existants. Le peptide serait également efficace sur des souches particulièrement résistantes de P. aeruginosa, d' E. coli et de S. aureus.
SOURCE : PLOS Pathogens
- Créé le .
